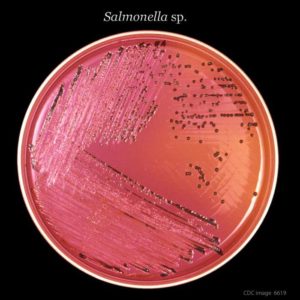

Salmonella Potsdam is a serovar that doesn’t get much attention but it popped up on the radar last week when the U.S. Food and Drug Administration (FDA) announced it was investigating a Salmonella Potsdam outbreak that has sickened at least seven people. The Centers for Disease Control and Prevention has not announced its involvement in the investigation and a potential food source has not yet been revealed.
A 2011 study by researchers from the Department of Veterinary Medicine, at Taiwan’s National Chiayi University, found that eggs from waterfowl and chickens have been found to be a source of the serovar. That seems to have been the case in one of the only documented outbreaks associated with the Salmonella Potsdam.
2002 Caesar Salad Dressing at New South Wales Restaurant
In 2002, 12 people who ate at a restaurant in New South Wales, Australia developed Salmonella Potsdam infections. Health officials collected swabs from the restaurant and found the outbreak strain in the egg-based Caesar salad dressing and in the cap of a mayonnaise bottle.
In the U.S., Salmonella Potsdam isn’t common. According to data from the CDC, between 2006 and 2016 just 238 cases were reported, a far cry from the tens of thousands of cases associated annually with more common serovars such a Salmonella Enteritidis (83,303), Salmonella Typhimurium (63,773), and Salmonella Newport (47,481).
2015-2016 Tongue and Tripe Appetizer at Connecticut Restaurant
In late 2015 and early 2016, the Connecticut Department of Public Health identified five laboratory-confirmed Salmonella Potsdam cases. During interviews with health officials, these case-patients all reported eating at the same restaurant and ordering the same tongue and tripe appetizer. Four additional probable cases were identified among customers who also consumed the appetizer.
Symptoms of a Salmonella infection include nausea, abdominal cramps, and diarrhea that can be bloody. Usually, these symptoms develop within six to 72 hours of exposure and last about a week. In about 10 percent of cases, Salmonella infections become invasive and require treatment in a hospital setting.
Contact the Pritzker Hageman Salmonella Legal Team Today
Phone: 612-338-0202 | Text: 1-612-261-0856